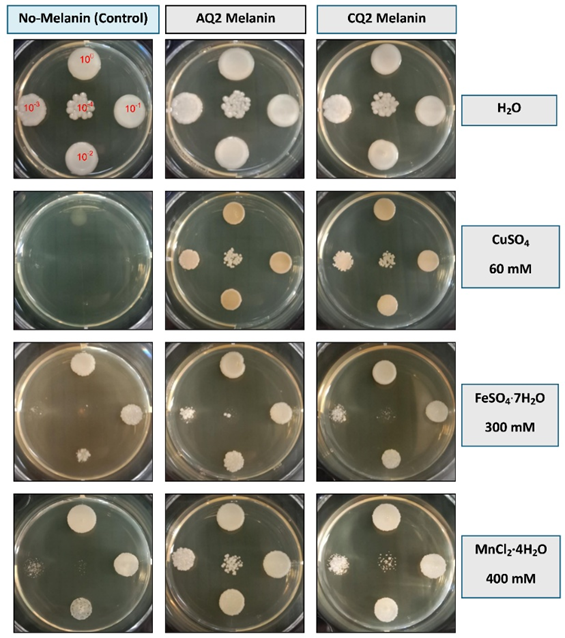

Trends
Sci.
2026;
23(5):
12213
Protective Effects and Metal Chelating Activity of Bacterial Melanin Produced by Streptomyces Spectabilis
Nattakarn Pengkasukunto1, Rattikarn Uasoontornnop1, Yamaratee Jaisin2,
Nattaya Jansongsaeng3, Pornphat Surasen3 and Srisombat Puttikamonkul1,*
1Department
of Microbiology, Faculty of Medicine, Srinakharinwirot University,
Bangkok 10110, Thailand
2Department
of Pharmacology, Faculty of Medicine, Srinakharinwirot University,
Bangkok 10110, Thailand
3Department of Microbiology, Faculty of Science, Srinakharinwirot University, Bangkok 10110, Thailand
(*Corresponding author’s e-mail: [email protected])
Received: 8 October 2025, Revised: 12 November 2025, Accepted: 19 November 2025, Published: 20 January 2026
Abstract
Melanin is a complex biopolymer widely distributed among diverse organisms and is recognized for its various biological functions, including antioxidant activity, ultraviolet (UV) protection, and metal ion chelation. In this study, melanin extracted from Streptomyces spectabilis strains AQ2 and CQ2 was analyzed in terms of its chemical characteristics and bioactivities. Experimental results indicated that melanin yields from both strains were generally comparable. Strain AQ2 exhibited slightly higher production efficiency relative to biomass, whereas strain CQ2 produced a marginally greater total amount of melanin after prolonged cultivation. The structural properties of the extracted melanin were subsequently examined using Fourier transform infrared (FTIR) and UV–visible spectroscopy. Spectroscopic analysis confirmed that the melanin displayed structural features and typical absorption characteristics of synthetic melanin. Assessment of antioxidant potential via 1,1-diphenyl-2-picrylhydrazyl (DPPH) radical scavenging and intracellular reactive oxygen species (ROS) assays using 2',7'-dichlorodihydrofluorescein diacetate (DCFH-DA) revealed that melanin from strain CQ2 exhibited superior free radical scavenging activity compared to AQ2. Moreover, melanin from both strains effectively reduced intracellular ROS levels following UV exposure in B16F10 and HaCaT cell lines. Additionally, both melanin demonstrated strong metal ion chelation activity, with particularly high affinity for copper ions. Collectively, these findings suggest that melanin from S. spectabilis strains AQ2 and CQ2 possess significant bioactive properties and holds promise as a natural agent for UV protection, antioxidant defense, and heavy metal remediation. Further studies should focus on optimizing production parameters and exploring broader functional applications of these natural melanin compounds.
Keywords: Melanin, Streptomyces spectabilis, Antioxidant activity, UV protection, Intracellular reactive oxygen species, Heavy metal, Bioremediation
Introduction
Melanin is a dark biopolymer composed primarily of phenolic and indolic monomers, and it is widely distributed across a variety of biological kingdoms, including animals, plants, and microorganisms [1]. Based on their chemical composition and biosynthetic pathways, melanin is generally classified into several types: Eumelanin, pheomelanin, allomelanin, neuromelanin, and pyomelanin. These pigments
originate from distinct precursors such as dihydroxyphenylalanine (DOPA), 1,8-dihydroxynaphthalene (DHN), 5,6-dihydroxyindole, catechol, and homogentisic acid (HGA). The molecular architecture of melanin is highly complex and heterogeneous, contributing to its wide range of chemical and physical properties [2,3].
Due to its structural complexity, melanin exhibits remarkable stability and resistance to diverse environmental stresses, including extreme temperatures, ultraviolet (UV) radiation, oxidative agents, and heavy metals [4]. These characteristics underpin its broad utility in various fields such as cosmetics, biomedicine, food technology, optoelectronics, and environmental remediation [5]. Recent studies have increasingly highlighted the biological activities of melanin. For example, melanin derived from Curvularia soli has demonstrated antibacterial properties against Klebsiella pneumoniae ATCC 13883 and Penicillium digitatum [6], while other forms of melanin have shown potent antioxidant activity through free radical scavenging and electron transfer capabilities [7,8]. Additionally, melanin isolated from Streptomyces djakartensis NSS-3 exhibited anticancer, antimicrobial, and radioprotective properties [9]. Water-insoluble melanin from Inonotus hispidus was found to reduce intracellular reactive oxygen species and protect embryonic liver cells under oxidative stress [10]. Furthermore, melanin from Stachybotrys sp. HSS-1 has demonstrated strong metal ion absorption capacity, indicating its potential for wastewater treatment applications [11].
As the global demand for natural bioactive compounds increases, microbial fermentation has emerged as a viable strategy for scalable and cost-effective melanin production [12]. Among melanin-producing microorganisms, actinomycetes, particularly the genus Streptomyces, are of notable interest due to their metabolic versatility and extensive biosynthetic capabilities [13]. Widely distributed in both terrestrial and marine environments, Streptomyces species are recognized for their prolific production of secondary metabolites, especially antibiotics, with individual strains often encoding the potential to produce 10 - 20 bioactive compounds [14]. Historically, members of this genus have contributed over two-thirds of clinically relevant natural antibiotics and continue to be a valuable source of compounds with antimicrobial, anticancer, enzymatic, and antioxidant activities [15-18].
Through screening of natural microbial isolates, two strains identified as S. spectabilis AQ2 and CQ2 were found to produce a dark pigment presumed to be melanin. However, no comprehensive study has yet confirmed the structural identity or bioactivity of this pigment. This study aims to address this knowledge gap by cultivating S. spectabilis strains AQ2 and CQ2 for melanin production. The extracted pigments will be characterized using UV–visible spectroscopy and Fourier transform infrared spectroscopy (FTIR) to confirm their structural identity. In addition, the biological properties of the melanin will be evaluated, with a focus on its antioxidant potential, ability to reduce intracellular reactive oxygen species to protect cells from UV exposure, and metal ion chelation capacity. The outcomes of this study are expected to provide valuable insights into the bioactive properties and potential applications of melanin derived from these microbial strains in the future.
Materials and methods
Cultivation of S. spectabilis strains AQ2 and CQ2
S. spectabilis strains AQ2 and CQ2, previously isolated from soil samples [19], were preserved in glycerol stocks at −20 °C. For recovery and proliferation, both strains were cultured on yeast malt agar (YMA; HIMEDIA, India) at 28 °C for 6 days. After cultivation, the strains were harvested using 0.01% Tween 80, transferred into potato dextrose broth (PDB; HIMEDIA, India), and incubated at 28 °C with continuous incubated at 28 °C, 200 rpm for 7 - 14 days. For inoculum preparation, bacterial cells from two fully grown agar plates were suspended in 100 mL of broth medium, which was considered the optimal volume for melanin production.
Melanin extraction
After cultivation, melanin was extracted from S. spectabilis following previously described methods with modifications [20]. The culture supernatant was separated from the microbial biomass by centrifugation at 4,500×g for 15 min. The pH of the supernatant was then adjusted to 2.0 using 6 M hydrochloric acid (HCl) and left at 25 °C for 24 h to allow crude melanin precipitation. The resulting precipitate was collected by centrifugation, washed four times with deionized water to remove residual impurities, and dried at 70 °C for 48 h to ensure complete dehydration. The yield of purified melanin was subsequently quantified using an analytical balance and expressed relative to the dry weight of the bacterial biomass.
Physicochemical properties
The extracted melanin from S. spectabilis AQ2 and CQ2 was analyzed using a FTIR spectrophotometer (PerkinElmer, USA) in the range of 4,500 - 400 cm−1, with synthetic melanin (Sigma Aldrich, United Kingdom) serving as a standard for comparison. This technique provided information on the infrared absorption bands corresponding to functional groups and molecular composition, thereby elucidating the chemical structure of the melanin. For UV-visible spectroscopic analysis, the melanin was dissolved in dimethyl sulfoxide (DMSO) to prepare a stock solution for use in other experiments, and its concentration was adjusted with 95% ethanol (EtOH). The UV-visible absorption spectrum was then recorded in the range of 200 - 900 nm using a UV-visible spectrophotometer (BIOBASE, China), with synthetic melanin as a reference standard. This analysis revealed the absorbance profile and characteristic peaks of the melanin.
Free radical scavenging activity assay
The antioxidant activity was evaluated using the 2,2-diphenyl-1-picrylhydrazyl (DPPH; Sigma-Aldrich, Germany) free radical scavenging assay, as previously described [21]. Different concentrations of melanin (1 - 5 mg/mL) from AQ2 and CQ2 were prepared in DMSO [22], with Trolox and ascorbic acid serving as positive controls at concentrations of 0.025, 0.05, 0.075, 0.1, and 0.125 mg/mL. The DPPH stock solution was prepared by dissolving DPPH powder in methanol to obtain a deep purple solution, and the absorbance at 515 nm. The OD was adjusted to 1.0 - 1.2 by dilution or concentration as necessary. An aliquot of 180 µL of DPPH solution was added to each well of a 96-well plate, followed by 20 µL of the melanin sample. After 15 min of incubation in the dark, absorbance was measured at 515 nm using a microplate reader (Bio-Tek Instruments, Winooski, Vermont, USA) to determine the scavenging activity. Methanol served as the negative control. The ability to scavenge the DPPH radical will be calculated by using the following Eq. (1).
Scavenging rate (%) = [ (A0 – A1)/A0]×100 (1)
where A0: DPPH + Methanol and A1: DPPH+melanin
Cell culture
The cell lines utilized in this study include the mouse melanocyte cell line (B16F10, ATCC) and the human keratinocyte cell line (HaCaT, Germany). These cell lines were cultured in growth medium containing 10% fetal bovine serum (FBS; HyCloneTM, USA), 100 IU/mL penicillin-streptomycin (HyCloneTM, Austria), and 1% non-essential amino acids (Millipore Sigma, USA), maintained in a humidified incubator at 37 °C with 5% CO₂. Once the cells reached approximately 80% confluence or form a confluent monolayer, the growth medium was replaced with Dulbecco’s phosphate-buffered saline (DPBS; Caisson, USA). The HaCaT cell line was incubated for 8 min with fresh 0.05% EDTA (ethylenediaminetetraacetic acid) in DPBS solution while the B16F10 cell line was soaked and washed with fresh DPBS solution. Both cells were subsequently detached with 0.125% trypsin. The cells were collected and counted to prepare for subsequent experimental assays [23,24].
Cytotoxicity evaluation and protective effect of melanin on B16F10 and HaCaT cell lines
Cytotoxicity was evaluated using the resazurin assay, modified as previously described [23]. The B16F10 and HaCaT cells were seeded into 96-well plates at a density of 2×104 and 5×10⁴ cells/well, respectively. After overnight attachment, cells were treated with melanin extracted from AQ2 and CQ2 at concentrations ranging from 0.125 to 50 µg/mL for 24 h, with DMSO-treated serve as the control. Cytotoxicity was determined using the resazurin cell viability assay (Sigma-Aldrich, USA), in which 20 µl of resazurin solution was added to each well and incubated for 2 h at 37 °C in a humidified atmosphere with 5% CO₂. Following incubation, fluorescence intensity was measured using a microplate reader (Bio-Tek Instruments, Winooski, Vermont, USA) at 530 nm excitation and 590 nm emission.
UV source and treatment
The UV Bio-Link BLX crosslinker (BIO-LINK®, Vilber Lourmat UV-Crosslinker, Deutschland GmbH, Eberhardzell, Germany) emitted UVA radiation ranging from 315 to 400 nm and UVB radiation from 280 to 320 nm, which was used to stimulate the cells. Prior to single exposure to UVA irradiation at 800 mJ/cm² and UVB irradiation at 80 mJ/cm², the culture medium was discarded, and the cells were washed with DPBS before being covered with a thin layer of DPBS [23].
Intracellular ROS level after UV exposure in B16F10 and HaCaT cell lines
The
intracellular ROS levels was evaluated using
2',7'-dichlorodihydrofluorescein diacetate (DCFH-DA; Sigma-Aldrich,
USA), as previously described with minor modifications [24]. For ROS
measurements, the B16F10 and HaCaT cells were seeded into 6-well
plates at a density of 6×10⁵ and 1×10⁶ cells/well,
respectively
once
the HaCaT cells formed a monolayer, they were treated with melanin
extracted from AQ2 and CQ2 at two concentrations (12.5 and 25 µg/mL)
for 24 h., while the B16F10 cells were treated differently; two
concentrations of AQ2 melanin (6.25 and 12.5 µg/mL), and two
concentrations of CQ2 melanin (12.5 and 25 µg/mL). DMSO-treated
cells served as controls and were divided into two groups:
Non-UV-exposed negative control and a UV-exposed positive control.
After 24 h of treatment, the cells were incubated with 10 µM
DCFH-DA for 20 min in the dark, followed by washing with DPBS. The
cells were then single exposed to UVA at dose of 800 mJ/cm² and to
UVB at dose of 80 mJ/cm² using a UV crosslinker, followed by
incubation with phenol red-free culture medium for 1 h. The
intracellular ROS levels were quantified by measuring fluorescence
at 485 nm (excitation) and 535 nm (emission) using a
microplate reader
(BioTek Instruments, Winooski, VT, USA).
Chelate metals ions activity
The metal ion-binding capability of melanin was evaluated using a viability assay, adapted from previously reported methods [12]. Stock solutions of metal salts (60 mM CuSO4, 300 mM FeSO4·7H2O, and 400 mM MnCl2·4H2O) were prepared in distilled water and individually incubated with melanin powders (5 mg) derived from AQ2 and CQ2. The mixtures were incubated at 25 °C for 24 h, followed by centrifugation at 10,000×g for 10 min to collect the supernatants. The collected supernatants were then incorporated into potato dextrose agar (PDA; HIMEDIA, India) at a 1:15 ratio, with separate groups designated as pre-incubation (metal alone; control group) and post-incubation (metal + melanin). Candida albicans were subsequently prepared in serial 10-fold dilutions ranging from 10⁸ to 10⁴ CFU/mL. A 10 µL aliquot of each dilution was spotted onto pre-prepared PDA plates to assess the effect of metals on fungal growth. This method allowed for the evaluation of both metal-mediated inhibition of C. albicans growth and the role of melanin in metal ion sequestration.
Statistical analysis
All experiments were repeated in at least 3 independent replicates, unless otherwise specified in each figure. The experimental data was analyzed using GraphPad 9 Software (GraphPad Software, LLC). Data from the DPPH assay will be expressed as mean ± standard deviation (𝑥̄ ± SD), while other results was presented as mean ± standard error of the mean (𝑥̄ ± SEM). Statistical significance was assessed using one-way ANOVA followed by Tukey’s multiple comparisons test, with p-value < 0.05 considered significant and 95% confidence intervals. The overall effect size and pairwise effect sizes were estimates by η² (eta-squared) and Cohen’s d, respectively.
Results and discussion
Melanin production of S. spectabilis Strains AQ2 and CQ2
The cultivation of S. spectabilis strains AQ2 and CQ2 exhibited distinct melanin production profiles. Strain AQ2, cultured in 1,000 mL of medium for 7 - 8 days, produced 4.23 g of bacterial biomass and 37.56 mg of melanin (0.89% yield), while CQ2, grown for 12 - 14 days, yielded 6.14 g of biomass and 51.88 mg of melanin (0.84% yield) (Figure 1). Although CQ2 produced a higher total amount of melanin, its longer cultivation period and lower biomass-specific yield indicate reduced efficiency. AQ2 synthesized melanin more rapidly, making it suitable for fast and efficient production, whereas CQ2 may be more appropriate for processes prioritizing total yield. Overall, both strains produced comparable amounts of melanin. These differences likely result from strain-specific enzymatic activities, variations in metabolic flux, or regulatory mechanisms in melanogenesis. Further genetic and transcriptomic studies are needed to clarify these factors and inform metabolic engineering strategies. Melanin yields remain lower than some microbial sources [25,26], but production can be enhanced through tyrosine supplementation, addition of metal ions, or adjustment of substrate concentrations, and accurate characterization of melanin remains critical for improving extraction and synthesis methods [19, 26-29].

Figure 1 Schematic representation of the cultivation and melanin production from S. spectabilis strains AQ2 and CQ2.
Table 1 Summary of the measured properties of melanin extracted from S. spectabilis strains AQ2 and CQ2.
Measured properties |
S. spectabilis AQ2 (Melanin) |
S. spectabilis CQ2 (Melanin) |
Production of melanin |
||
Cultivation time (days) |
7 - 8 |
12 - 14 |
Yield (%) |
0.89 |
0.84 |
Physicochemical properties of melanin |
||
FTIR analysis (cm-1) |
3274.60 1636.50 772.45 |
3274.60 1636.50 772.45 |
UV absorption |
230 - 250 nm |
230 - 250 nm |
Antioxidant Activity of melanin (mg/mL) |
||
IC₅₀ |
6.47 |
5.01 |
Cytotoxicity of melanin (µg/mL) |
||
B16F10 cells |
25 |
50 |
HaCaT cells |
50 |
50 |
Reduction of intracellular ROS level by melanin (µg/mL) |
||
Melanin treatment & UVA treated B16F10 cells |
F (3, 12) = 46.17, p-value < 0.0001 η² = 0.9203 Cohen’s d = 2.22 - 7.78 |
F (3,12) = 25.72, p-value < 0.0001 η² = 0.8651 Cohen’s d = 0.61 - 5.87 |
Melanin treatment & UVB treated B16F10 cells |
F (3,12) = 27.06, p-value < 0.0001 η² = 0.8712 Cohen’s d = 4.01 - 6.05 |
F (3,12) = 65.18, p-value < 0.0001 η² = 0.9422 Cohen’s d = 3.36 - 9.70 |
Melanin treatment & UVA treated HaCaT cells |
F (3,12) = 184.3, p-value < 0.0001 η² = 0.9788 Cohen’s d = –0.16 to –16.18 |
F (3,12) = 53.18, p-value < 0.0001 η² = 0.9301 Cohen’s d = 0.025 - 8.88 |
Melanin treatment & UVB treated HaCaT cells |
F (3,12) = 86.18, p-value < 0.0001 η² = 0.9556 Cohen’s d = 4.59 to 11.29 |
F (3,12) = 139.9, p-value < 0.0001 η² = 0.9722 Cohen’s d = 2.47 to 14.14 |
Metal ion chelation activity of melanin (C. albicans fold growth over control) |
||
60 mM Cu2+ |
++++ (104-fold) |
++++ (104-fold) |
300 mM Fe2+ |
+ (10-fold) |
+ (10-fold) |
400 mM Mn2+ |
++ (102-fold) |
++ (102-fold) |
* Metal ion chelation activity: (+), (++) indicates the ability to chelate heavy metal ions; (++++) indicates a pronounced ability to chelate heavy metal ions.
Physicochemical properties
Melanin extracted from both S. spectabilis strains exhibited chemical characteristics closely resembling synthetic melanin, indicating structural authenticity and functional relevance. FTIR analysis revealed absorption bands around 3,200 - 3,300 cm−1, corresponding to –NH and –OH groups in indole rings, suggesting hydrogen bonding that stabilizes the melanin structure. Peaks at 1,620 - 1,650 cm−1 indicated C=O and N–H stretching of amide groups, confirming peptide bonds and the polymeric nature of the pigment. Absorption in the 600 - 800 cm−1 range, associated with low-frequency aromatic hydrogen vibrations, validated the aromatic and highly conjugated backbone typical of melanin [6,12,30,31] (Figure 2(A)). UV–visible spectroscopy further revealed strong UV absorption by both extracted melanin samples, with peaks observed between 230 - 250 nm. This absorption extended across both UVA and UVB wavelength ranges and closely matched synthetic melanin standards [9,26,31,32]. Notably, melanin extracted from strain CQ2 exhibited stronger UV absorption than that from AQ2 (Figure 2(B)). Collectively, these spectroscopic features demonstrate that S. spectabilis-derived melanin possesses both structural and photoprotective properties comparable to synthetic melanin, highlighting its potential as a bio-based UV-protective pigment.

Figure 2 Physicochemical characterization of melanin extracted from S. spectabilis strains AQ2 and CQ2, showing (A) Fourier transform infrared spectroscopy (FTIR) and (B) UV–visible absorption spectra, with STD (control) representing synthetic melanin.
Antioxidant activity
The antioxidant activity of melanin extracted from S. spectabilis strains AQ2 and CQ2, as determined by the DPPH assay, demonstrated measurable free radical scavenging capacity, reflecting its potential as a natural antioxidant. This observation was consistent with FTIR results, where absorption bands around 3,200 - 3,300 cm⁻¹ corresponded to –NH and –OH groups. These –NH and –OH groups in indolic structures contribute to antioxidant activity through electron donation [4], thereby stabilizing free radicals. Furthermore, the results aligned with previous reports indicate that naturally derived melanin possesses free radical scavenging properties [7,8,33,34]. Melanin from strain CQ2 consistently exhibited higher scavenging activity than that from AQ2 across all tested concentrations (1 - 5 mg/mL) (Figure 3), suggesting strain-dependent efficiency that may be associated with structural variations, differences in the degree of polymerization, or the presence of functional groups influencing electron-donating capacity. Despite these effects, the antioxidant activity of both melanin samples remained significantly lower than that of standard antioxidants, such as Trolox and ascorbic acid, which exhibited IC₅₀ values of 0.111 and 0.069 mg/mL, respectively, demonstrating a substantially stronger radical-neutralizing capacity. In comparison, AQ2- and CQ2-derived melanin exhibited IC₅₀ values of 6.47 and 5.01 mg/mL, respectively, with IC₅₀ determined by plotting DPPH scavenging activity against sample concentrations. These findings suggest that, while S. spectabilis melanin has intrinsic antioxidant properties, its standalone efficacy is moderate. Therefore, selecting appropriate strains and further exploring its potential properties are necessary to improve its antioxidant performance.

Figure 3 Antioxidant activity of melanin extracted from S. spectabilis strains AQ2 and CQ2, showing DPPH radical scavenging activity at concentrations of 1 - 5 mg/mL. Data were presented as mean ± SD (n = 4).
Cytotoxicity evaluation of melanin on B16F10 and HaCaT cell lines
Cytotoxicity assays were conducted to determine the appropriate concentration range of melanin for evaluating its UV-protective properties. Previous studies have indicated that melanin exhibits lower cytotoxicity toward normal cells compared with cancerous cells. The concentrations tested in this study included 0.125, 0.25, 0.5, 1, 3.125, 6.25, 12.5, 25, and 50 µg/mL. Melanin extracted from S. spectabilis strain AQ2 exhibited significant cytotoxicity toward melanocyte cells at 25 µg/mL (p-value < 0.0001) versus the control group, whereas significant cytotoxicity toward keratinocyte cells was observed at 50 µg/mL (p-value < 0.0001) versus the control group (Figures 4(A) and 4(B)). In contrast, melanin derived from strain CQ2 demonstrated significant cytotoxic effects in both melanocyte and keratinocyte cells only at 50 µg/mL (p-value < 0.0001) versus the control group (Figures 4(A) and 4(B)), indicating relatively lower cytotoxicity compared with AQ2-derived melanin at equivalent concentrations. Previous studies in the rat H9c2 cardiomyocytes have reported that melanin exhibits low toxicity at low concentrations [35]. Therefore, these findings underscore the importance of careful concentration optimization when applying melanin as a UV-protective agent, as cytotoxicity profiles vary between strains. In particular, lower concentrations should be selected for AQ2-derived melanin to ensure reliable and reproducible results in subsequent UV-protection assays.

Figure 4 Cytotoxic effects of various concentrations ranging from 1 to 50 µg/mL of melanin extracted from S. spectabilis strains AQ2 and CQ2 on B16F10 cells (A, B) and HaCaT cells (C, D) after 24 h. Data were presented as mean ± SEM (n = 4) and were analyzed using one-way ANOVA followed by Tukey’s multiple comparisons test. ###; p-value < 0.001 versus the control group.
Intracellular ROS level after UV exposure in B16F10 and HaCaT cells
The evaluation of intracellular reactive oxygen species (ROS) levels following single UVA and UVB exposure in melanocyte (B16F10) and keratinocyte (HaCaT) cell lines highlighted the antioxidant potential of melanin extracted from S. spectabilis strains AQ2 and CQ2. Overall, UVA irradiation induced higher ROS levels than UVB, indicating that UVA serves as a more significant contributor to oxidative stress. Treatment of B16F10 cells with AQ2-derived melanin at concentrations of 6.25 and 12.5 µg/mL significantly reduced intracellular ROS levels in melanocytes under UVA exposure, with p-values of 0.0135 and <0.0001, respectively (Figure 5(A); B16F10-AQ2-UVA). The effect size analysis using Eta-squared indicating an extremely strong overall effect (η² = 0.9203) (Table 1). Moreover, the pairwise effect sizes calculated using Cohen’s d ranged from 2.22 to 7.78, confirming that the observed differences between treatment groups were not only statistically significant but also biologically substantial, with very large to extremely large standardized mean differences. Similarly, CQ2-derived melanin at 12.5 and 25 µg/mL markedly decreased ROS levels, with statistically significant effects (p-value = 0.0005 and 0.0001, respectively), and exhibited a slightly higher ROS reduction than AQ2 (Figure 5(B); B16F10-CQ2-UVA). The effect size (η² = 0.8651), indicating that 86.51% of the variance was attributable to treatment (Table 1).
In addition, one-way ANOVA revealed a highly significant impact of UVB exposure and melanin concentration on B16F10 cells. Only CQ2-derived melanin demonstrated statistically significant reductions at 12.5 and 25 µg/mL (p-value = 0.0015 and 0.0023, respectively) (Figure 6(B); B16F10-CQ2-UVB). Post hoc comparisons using Tukey’s test showed significant differences for all group comparisons (p-value < 0.01) except for 12.5 vs 25 µg/mL and pairwise effect size analysis (Cohen’s d) revealed extremely large effects ranging from d = 3.36 to 9.70, confirming substantial biological impact (Table 1). The AQ2-derived melanin showed no significant effects on the reduction of ROS compared to the UVB exposed control cells (Figure 6(A); B16F10-AQ2-UVB). The comparatively lower efficacy of AQ2 melanin may be attributed to the lower concentrations of tested melanin on the melanocyte (B16F10).
In
keratinocytes (HaCaT), melanin from both AQ2 and CQ2 significantly
inhibited ROS generation following single UVA and UVB irradiation,
demonstrating comparable antioxidant activities at 12.5 and 25 µg/mL
of both strains derived melanin. Both concentrations AQ2-derived
melanin significantly reduced intracellular ROS levels under UVA
exposure, with p-values
<0.0001 and <0.0001 (Figure
5(C);
HaCaT-AQ2-UVA). Post hoc comparisons using Tukey’s test revealed
statistically significant and biologically substantial differences
between all treatment groups, except between 12.5 and 25 µg/mL.
Effect sizes calculated with Cohen’s d ranged from –0.16 to
–16.18, confirming negligible to extremely large biological
effects depending on the comparison
(Table
1).
Similarly, CQ2-derived melanin at 12.5 and 25 µg/mL markedly
decreased ROS levels, with statistically significant effects
(p-values
0.0009 and 0.0009) (Figure
5(D);
HaCaT- CQ2-UVA). Corresponding Cohen’s d values ranged, supporting
the presence of strong biological effects in most treatment
comparisons (Table
1).
The
AQ2-derived melanin at concentration of 12.5 and 25 µg/mL treatment
on HaCaT cells showed a significant reduced ROS levels compared to
UVB exposed cells at p-values
0.0001 and 0.0002
(Figure
6(C);
HaCaT-AQ2-UVB), while similar concentration of CQ2-derived melanin
had significant effect at p-values
0.0002 and <0.0001 (Figure
6(D);
HaCaT-CQ2-UVB), respectively. Moreover, pairwise effect sizes
(Cohen’s d) of both strains-derived melanin, indicating large to
extremely large biological effects across treatment conditions
(Table
1).
Together data of UVA and UVB exposure among 2 different cell types
suggested that reductions in ROS were significantly reduced under
melanin treatment of UVB-induced oxidative stress compared with
untreated controls and greater pronounced under UVA-induced
oxidative stress. Collectively, these findings confirm that AQ2- and
CQ2-derived melanin effectively alleviates UV-induced oxidative
stress by reducing intracellular ROS levels, consistent with the
protective role of melanin against UV radiation [36]. Furthermore,
these cellular results correlate with the DPPH free radical
scavenging assay and UV–visible absorption data, which
demonstrated that both melanin possess intrinsic antioxidant and
UV-absorbing properties, with CQ2 exhibiting superior performance in
both aspects. In agreement with previous studies, melanin such as
those from Ophiocordyceps
sinensis
and Inonotus
hispidus
similarly reduced intracellular ROS [10,12]. Overall, the results
emphasize the potential of AQ2- and CQ2-derived melanin as promising
bioactive ingredients for UV-protective and skin-care formulations
designed to mitigate oxidative damage.

Figure 5 Effects of melanin from S. spectabilis strains AQ2 and CQ2 on evaluation of intracellular reactive oxygen species (ROS) levels after pre-incubation followed by single UVA irradiation. Panels (A), (B) show B16F10 cells, and panels (C), (D) show HaCaT cells. The relative fluorescence intensities are mean ± SEM (n = 4) and analyzed using one-way ANOVA followed by Tukey’s multiple comparisons test. ###; p-value < 0.001 versus the control group, *; p-value < 0.05, and ***; p-value < 0.001 versus UVA irradiated cells alone. The statistical difference between the melanin concentration was at $$; p-value < 0.01.

Figure 6 Effects of melanin from S. spectabilis strains AQ2 and CQ2 on evaluation of intracellular reactive oxygen species (ROS) levels after pre-incubation followed by single UVB irradiation. Panels (A), (B) showed B16F10 cells, and panels (C), (D) showed HaCaT cells. The relative fluorescence intensities were mean ± SEM (n = 4) and analyzed with Tukey’s test. ###; p-value < 0.001 versus the control group **; p-value < 0.01, and ***; p-value < 0.001 versus UVB irradiated cells alone, ns; non-significant versus UVB irradiated cells alone. The statistical difference between the melanin concentration was at $; p-value < 0.05.
Metal ion chelation activity
Previous studies have reported that naturally derived melanin can chelate various heavy metals, including iron, manganese, magnesium, zinc, and copper [37-39]. In this study, melanin samples from strains AQ2 and CQ2 showed strong chelation activity against CuSO4, FeSO4·7H2O and MnCl2·4H2O, at a concentration of 5 mg. Chelation efficiency was evaluated based on the growth of C. albicans on agar plates supplemented with metal solutions pretreated with melanin (Figure 7). For FeSO4·7H2O and MnCl2·4H2O, untreated metal solutions inhibited fungal growth, allowing growth only at 106 CFU/mL (10−2 dilution). In contrast, melanin-preincubated metal solutions supported increased C. albicans viability: Up to 10-fold growth of C. albicans over control (105 CFU/mL at a spot of 10−3 dilution) for FeSO4·7H2O and 102-fold growth of C. albicans over control (104 CFU/mL at a spot of 10−4 dilution) for MnCl2·4H2O. Among the tested ions, CuSO4 exhibited the most pronounced toxicity; untreated Cu²⁺ completely inhibited fungal growth at all concentrations. However, melanin pretreatment restored viability up to 104-fold growth of C. albicans over control (104 CFU/mL at a spot of 10−4 dilution), indicating strong sequestration of copper ions. These findings are consistent with previous reports describing the high copper-binding affinity of natural melanin [12,40]. The presence of functional groups such as hydroxyl, carboxyl, and indolic moieties likely contributes to metal coordination, in agreement with FTIR analysis showing –NH and –OH groups that not only stabilize the melanin structure via hydrogen bonding but also serve as active chelating sites. Overall, the metal ion chelation assay demonstrated that melanin extracted from S. spectabilis strains AQ2 and CQ2 possesses comparable heavy metal-binding capability. Notably, both extracts exhibited strong potential for copper detoxification, underscoring their applicability as natural chelating agents in biotechnological approaches for environmental remediation and mitigation of heavy metal pollution [11].
Figure 7 Effects of melanin on metal ion-induced inhibition of Candida albicans growth 24 h. Preincubated melanin in heavy metal prior 1:15 supernatant supplemented in PDA and growth inhibition was perform by 10 µL spot of serial diluted C. albicans from 10⁸ - 104 CFU/mL (as shown in the control plate; 10⁰ - 10−4 dilution), where “No-Melanin” represents the control group without pre-incubation of heavy metals with melanin.
Conclusions
Melanin produced by S. spectabilis strains AQ2 and CQ2 exhibited promising bioactive properties, particularly in UV protection and heavy metal chelation. Both strains yielded comparable amounts of melanin, with AQ2 showing higher production efficiency per biomass, whereas CQ2 produced larger quantities during prolonged cultivation. The extracted melanin exhibited both UV absorption and antioxidant activity, which effectively reduced intracellular ROS levels in melanocytes and keratinocytes after exposure to UVA and UVB radiation. The superior performance of CQ2-derived melanin under UVA irradiation is likely due to its drastically greater UV absorption range compared to the AQ2-derived variant (Figures 2 and 5(B) - 5(D)). Additionally, both melanin samples exhibited significant copper ion chelation capacity. These findings reinforce the benefits and previously recognized properties of naturally derived melanin, suggesting that melanin from S. spectabilis strains AQ2 and CQ2 function as a natural antioxidant and metal chelator, with potential for future development in cosmetic, pharmaceutical, and environmental remediation applications. However, several limitations remain in this study, including the need for purer extraction processes and more comprehensive physicochemical characterization. Techniques such as pyrolysis–gas chromatography–mass spectrometry (Py-GC-MS) could be employed to analyze structural components, while inductively coupled plasma–mass spectrometry (ICP-MS) would allow for more accurate evaluation of heavy metal adsorption capacity. Moreover, further systematic studies and optimizations are required to thoroughly investigate and enhance the protective and metal-chelating efficiencies of natural melanin. These efforts aim to maximize its performance and reliability for potential commercial applications, thereby ensuring that this bacterially derived melanin can be effectively utilized for advanced research and future product development.
Acknowledgements
This work was supported by a research grant from HRH Princess Mahachakri Sirindhorn Medical Center, Faculty of Medicine, Srinakharinwirot University (Contract No 289/2567), Thailand.
Declaration of Generative AI in Scientific Writing
This research utilized ChatGPT (GPT-5 mini) solely to assist in refining wording and phrasing. All scientific content, analysis, and conclusions were independently developed by the authors.
CRediT Author Statement
Nattakarn Pengkasukunto: Methodology; Validation, Formal analysis; Investigation; Writing – Original Draft Data Curation. Rattikarn Uasoontornnop: Methodology; Investigation; Formal analysis, Data Curation. Yamaratee Jaisin: Conceptualization; Methodology; Resources; Writing – Review & Editing. Nattaya Jansongsaeng: Preliminary methodology; investigation. Pornphat Surasen: Preliminary methodology; investigation. Srisombat Puttikamonkul: Conceptualization; Methodology; Resources; Writing – Review & Editing; Supervision; Project administration; Funding acquisition.
Reference
[1] ME Pavan, NI López and MJ Pettinari. Melanin biosynthesis in bacteria, regulation and production perspectives. Applied Microbiology and Biotechnology 2020; 104(4), 1357-1370.
[2] W Cao, X Zhou, NC McCallum, Z Hu, QZ Ni, U Kapoor, CM Heil, KS Cay, T Zand, AJ Mantanona, A Jayaraman, A Dhinojwala, DD Deheyn, MD Shawkey, MD Burkart, JD Rinehart and NC Gianneschi. Unraveling the structure and function of melanin through synthesis. Journal of the American Chemical Society 2021; 143(7), 2622-2637.
[3] AN Tran-Ly, C Reyes, FWMR Schwarze and J Ribera. Microbial production of melanin and its various applications. World Journal of Microbiology and Biotechnology 2020; 36(11), 170.
[4] HC Eisenman, EM Greer and CW McGrail. The role of melanins in melanotic fungi for pathogenesis and environmental survival. Applied Microbiology and Miotechnology 2020; 104(10), 4247-4257.
[5] NEA El-Naggar and WIA Saber. Natural melanin: Current trends, and future approaches, with especial reference to microbial source. Polymers, 2022; 14(7), 1339.
[6] AS Abd-EL-Aziz, NN Abed, AY Mahfouz and RM Fathy. Production and characterization of melanin pigment from black fungus Curvularia soli AS21 ON076460 assisted gamma rays for promising medical uses. Microbial Cell Factories 2024; 23(1), 68.
[7] MI Sheefaa and P Sivaperumal. Antioxidant activities from melanin pigment produced by marine actinobacterium of Streptomyces species. Journal of Advanced Pharmaceutical Technology & Research 2022; 13(S1), S84-S87.
[8] X Fu, M Xie, M Lu, L Shi, T Shi and M Yu. Characterization of the physicochemical properties, antioxidant activity, and antiproliferative activity of natural melanin from S. reiliana. Scientific Reports 2022; 12(1), 2110.
[9] NA El-Zawawy, ER Kenawy, S Ahmed and S El-Sapagh. Bioproduction and optimization of newly characterized melanin pigment from Streptomyces djakartensis NSS-3 with its anticancer, antimicrobial, and radioprotective properties. Microbial Cell Factories 2024; 23(1), 23.
[10] X Li, W Wu, F Zhang, X Hu, Y Yuan, X Wu and J Fu. Differences between water-soluble and water-insoluble melanin derived from Inonotus hispidus mushroom. Food Chemistry X 2022; 16, 100498.
[11] Z Peng, S Luo, D Zhao and J Zhang. Biosynthetic melanin with excellent performance can be used for heavy metal adsorption. Journal of Cleaner Production 2023; 385, 135655.
[12] C Tong, J Luo, C Xie, J Wei, G Pan, Z Zhou and C Li. Characterization and biological activities of melanin from the medicinal fungi Ophiocordyceps sinensis. International Journal of Molecular Sciences 2023; 24(12), 10282.
[13] JWF Law, LNS Law, V Letchumanan, LTH Tan, SH Wong, KG Chan, NSA Mutalib and LH Lee. Anticancer drug discovery from microbial sources: The unique mangrove Streptomycetes. Molecules 2020; 25(22), 5365.
[14] SD Bentley, KF Chater, AM Cerdeño-Tárraga, GL Challis, NR Thomson, KD James, DE Harris, MA Quail, H Kieser, D Harper, A Bateman, S Brown, G Chandra, CW Chen, M Collins, A Cronin, A Fraser, A Goble, J Hidalgo, T Hornsby, S Howarth, CH Huang, T Kieser, L Larke, L Murphy, K Oliver, S O’Neil, E Rabbinowitsch, MA Rajandream, K Rutherford, S Rutter, K Seeger, D Saunders, S Sharp, R Squares, S Squares, K Taylor, T Warren, A Wietzorrek, J Woodward, BG Barrell, J Parkhill and DA Hopwood. Complete genome sequence of the model actinomycete Streptomyces coelicolor A3(2). Nature 2002; 417(6885), 141-147.
[15] K Alam, A Mazumder, S Sikdar, YM Zhao, J Hao, C Song, Y Wang, R Sarkar, S Islam, Y Zhang and A Li. Streptomyces: The biofactory of secondary metabolites. Frontiers in Microbiology 2022; 13, 968053.
[16] S Rammali, L Hilali, K Dari, B Bencharki, A Rahim, M Timinouni, F Gaboune, ME Aalaoui and A Khattabi. Antimicrobial and antioxidant activities of Streptomyces species from soils of three different cold sites in the Fez-Meknes region Morocco. Scientific Reports 2022; 12(1), 17233.
[17] S Rammali, FZ Kamal, ME Aalaoui, B Bencharki, V Burlui, A Khattabi, A Abderrahim, S Saad, L Romila, B Novac, R Aitlhaj-Mhand, AD Petroaie and A Ciobică. In vitro antimicrobial and antioxidant activities of bioactive compounds extracted from Streptomyces africanus strain E2 isolated from Moroccan soil. Scientific Reports 2024; 14(1), 27372.
[18] GC Ashok, SP Pradhan, KK Karki, A Khadka, A Bhandari and BP Pandey. Antioxidant and enzyme inhibitory potential of Streptomyces sp. G-18 grown in various media. International Journal of Microbiology 2023; 2023, 6439466.
[19] R Uasoontornnopa, N Pengkasukuntoa, T Suwannarata, C Dhanasarnsombata, K Wannakomateb, B Wichachatb, M Namsa-Aidc and S Puttikamonkul. Enhancing the production of secreted melanin by Streptomyces spp. using common tyrosine-containing media. ScienceAsia 2025; 51(3), 1.
[20] T Kordjazi, L Mariniello, CVL Giosafatto, R Porta, OF Restaino. Streptomycetes as microbial cell factories for the biotechnological production of Melanin. International Journal of Molecular Sciences 2024; 25(5), 3013.
[21] P Namchaiw, Y Jaisin, C Niwaspragrit, K Malaniyom, A Auvuchanon and P Ratanachamnong. The leaf extract of Coccinia grandis (L.) Voigt accelerated in vitro wound healing by Reducing oxidative stress injury. Oxidative Medicine and Cellular Longevity 2021; 2021, 3963510.
[22] IE Pralea, RC Moldovan, AM Petrache, M Ilieș, SC Hegheș, I Ielciu, R Nicoară, M Moldovan, M Ene, M Radu, A Uifălean and CA Iuga. From extraction to advanced analytical methods: The challenges of melanin analysis. International Journal of Molecular Sciences 2019; 20(16), 3943.
[23] K Malaniyom, P Ratanachamnong, P Namchaiw, U Namdaung, S Suksamrarn and Y Jaisin. Suppression of the inflammatory response by oxyresveratrol from the root bark of Artocarpus lakoocha Roxb against ultraviolet B-induced keratinocytes mediated by regulating p38 MAPK and AP-1. Heliyon 2024; 10, e38962.
[24] S Natewong, C Niwaspragrit, P Ratanachamnong, P Samatiwat, P Namchaiw and Y Jaisin. Photo-protective and anti-inflammatory effects of Antidesma thwaitesianum Müll. Arg. fruit extract against UVB-Induced keratinocyte cell damage. Molecules 2022; 27(15), 5034.
[25] KM Elattar, AA Ghoniem, AA Al-Askar, UB El-Gazzar, MS El-Hersh, EA Elsherbiny, NM Eldadamony and WIA Saber. Melanin synthesized by the endophytic Aureobasidium Pullulans AKW: A multifaceted biomolecule with antioxidant, wound healing, and selective anti-cancer activity. Current Topics in Medicinal Chemistry 2024; 24(24), 2141-2160.
[26] A Elsayis, SWM Hassan, KM Ghanem and H Khairy. Optimization of melanin pigment production from the halotolerant black yeast Hortaea werneckii AS1 isolated from solar salter in Alexandria. BMC Microbiology 2022; 22(1), 92.
[27] WB Medeiros, KJD Medina and SRP Sponchiado. Improved natural melanin production by Aspergillus nidulans after optimization of factors involved in the pigment biosynthesis pathway. Microbial Cell Factories 2022; 21(1), 278.
[28] SY Ahn, S Jang, PDVN Sudheer and KY Choi. Microbial production of melanin pigments from caffeic acid and L-tyrosine using Streptomyces glaucescens and FCS-ECH-expressing Escherichia coli. International Journal of Molecular Sciences 2021; 22(5), 2413.
[29] HS Lee, JY Choi, SJ Kwon, ES Park, BM Oh, JH Kim and PC Lee. Melanin biopolymer synthesis using a new melanogenic strain of Flavobacterium kingsejongi and a recombinant strain of Escherichia coli expressing 4-hydroxyphenylpyruvate dioxygenase from F. kingsejongi. Microbial Cell Factories 2022; 21(1), 75.
[30] M Rudrappa, S Kumar, RS Kumar, AI Almansour, K Perumal and S Nayaka. Bioproduction, purification and physicochemical characterization of melanin from Streptomyces sp. strain MR28. Microbiological Research 2022; 263, 127130.
[31] A Ammanagi, CT Shivasharana, R Krishnaveni, A Badiger and V Ramaraj. Functional and structural characterization of melanin from Brevibacillus invocatus strain IBA. Biological Sciences Sections 2021; 500(1), 159-169.
[32] W Wilson, D Lowman, J Puthumana, R Kuriakose, ISB Singh and R Philip. Biocompatible melanin from the marine black yeast Hortaea werneckii R23 with antioxidant and photoprotection property. Brazilian Journal of Microbiology 2024; 55(4), 3171-3186.
[33] M Asril, RI Astuti, I Rusmana and AT Wahyudi. Characterization and antioxidant activity of eumelanin produced by Streptomyces lasalocidi NTB 42. Biocatalysis and Agricultural Biotechnology 2024; 61, 103361.
[34] NE El-Naggar and SM El-Ewasy. Bioproduction, characterization, anticancer and antioxidant activities of extracellular melanin pigment produced by newly isolated microbial cell factories Streptomyces glaucescens NEAE-H. Scientific Reports 2017; 7, 42129.
[35] A Chen, J Sun, S Liu, L Li, X Peng, L Ma and R Zhang. Effect of metal ions on endogenous melanin nanoparticles for magnetic resonance imaging contrast agents. Biomaterials Science 2020; 8, 379.
[36] M Mucha, E Skrzydlewska and A Gęgotek. Natural protection against oxidative stress in human skin melanocytes. Communications Biology 2025; 8(1), 1283.
[37] P Verma, S Krishnan, SC Seleyi, R Jaiswal, M Peter and G Dharani. Harnessing melanin from deep-sea yeast Hortaea werneckii NIOT129A8: Heavy metal adsorption potential. Marine Environmental Research 2025; 209, 107192.
[38] N El-Gazzar, E Abdo, G Rabie and MT El-Sayed. Suppression of mycotoxins production and efficient chelation of heavy metals using natural melanin originated from Aspergillus flavus and Aspergillus carbonarius. BMC Biotechnology 2025; 25(1), 6.
[39] L Hong, Y Liu and JD Simon. Binding of metal ions to melanin and their effects on the aerobic reactivity. Photochemistry and Photobiology 2004; 80(3), 477-481.
[40] L Hong and JD Simon. Insight into the binding of divalent cations to Sepia eumelanin from IR absorption spectroscopy. Photochemistry and Photobiology 2006; 82(5), 1265-1269.